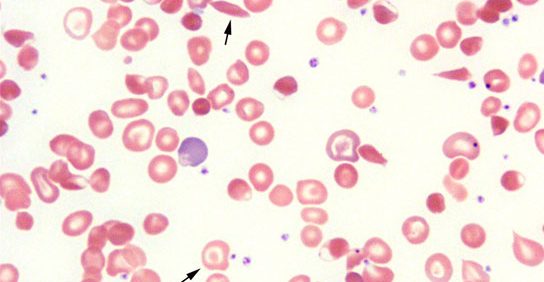

Akdeniz Anemisi çocuðu Olur Mu

Düzenli kan nakli ve demir atımı tedavisi gören hastada hormonal bozukluklar olmaz ve sağlıklı bir çocuğu olabilir.
Akdeniz anemisi çocuðu olur mu. Anemi kansızlık oluşmasına neden olan etmen kanda alyuvarların yapısında yer alan hemoglobin maddesinin yapımındaki kusurdur. Akdeniz ülkelerindeki ırklarda görülen doğacak çocuğa anne babasından beta talasemi geninin sirayetiyle kalıtımsal olarak geçen bir çeşit kansızlık hastalığıdır. Akdeniz anemisi ölümcül bir hastalık değildir. Böbrek hastalığı ve anemisi olan kişilerde kalp problemlerinin ortaya çıkması daha olasıdır.
5 6 aydan sonra kansızlık belirtileri ortaya çıkar. Bu rahatsızlık özellikle akdeniz ülkelerinde daha çok rastlandığından dolayı akdeniz anemisi adı ile anılır. Ağır sıvı kaybı hayati tehlike yaratabilir. Anemi ayrıca başka pek çok sağlık sorununa neden olabilir.
Diz protezi ameliyatlarında robotik cerrahi dönemi. Günümüzde tıp dünyasındaki gelişmeler sayesinde hastaların hayat kalitesini ve yaşam süresini artırarak talasemi kontrol altına alınabilmektedir. Bu hastalıkta taşıyıcı olanlara herhangi bir tedavi uygulanmasına gerek olmaz. Ancak evli çiftlerden ikisi de taşıyıcı olursa çocuklarının doğuştan akdeniz anemisi hastası olması daha yüksek bir risktir.
Akdeniz anemisi talasemi nedenleri ve tedavisi hakkındaki bilgi almak akdeniz anemisi talasemi hastalığı ile ilgili uzman doktorlarla iletişim kurmak ve randevu almak için tıklayın. Akdeniz anemisi belirtileri akdeniz anemisi olan çocuk doğduğunda normaldir. Akdeniz anemisi ölümcül müdür. Bu aylardaki çocuklarda kansızlık en çok demir eksikliğinden kaynaklandığı için ilk akla gelen demir eksikliği anemisidir ve hatalı olarak demir tedavisi yapılır.
Talasemili hasta sağlıklı bir kişi ile evlenirse çocuğu taşıyıcı olur. Hemoglobinler kırmızı kan hücrelerinde bulunan ve demir protein bakımından zengin olan bir maddedir. Akdeniz anemisi ya da tıptaki adıyla talasemi. Akdeniz anemisi taşıyıcısı talasemi dünyanın değişik birçok ülkesinde rastlanan ebeveynlerden bebeklere geçen ırsi bir tür kan hastalığıdır.
Reflüsü olanlar nasıl beslenmeli. Akdeniz anemisi mutasyona uğramış genlerin vücudun sağlıklı hemoglobin üretimini durdurmasıyla ortaya çıkar.